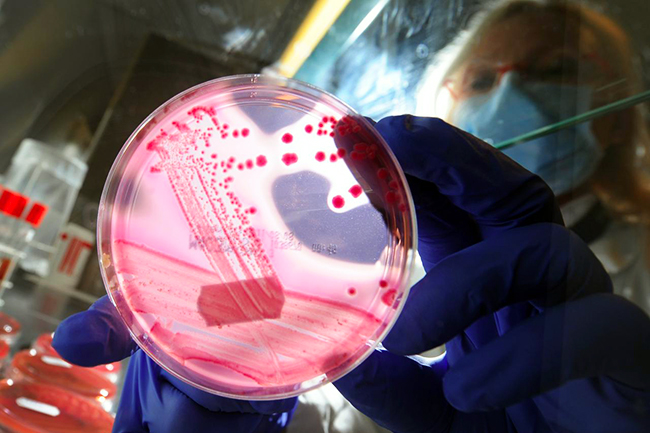

Супербактерије прете човечанству
СВЕ ИХ ЈЕ ВИШЕ, А ОТПОРНЕ НА СВЕ ПОЗНАТЕ АНТИБИОТИКЕ И НАЧИНЕ ЛЕЧЕЊА
Супербактерија MRSA
Супербактерија MRSA
- Једна од најпознатијих супербактерија MRSA у Сједињеним Америчким Државама годишње усмрти безмало 19.000 особа, знатно више него AIDS. Отприлике исто толико људи страда од ове бактерије и у ЕУ
- Неке врсте туберкулозе и гонореје отпорне на све врсте познатих антибиотика, а међу новим „суперсупербактеријама“ најпознатија NDM1 која се пре неку годину први пут откривена у Индији, а данас се са њом сусрећу лекари од Британије до Новог Зеланда
ОТПОРНОСТ бактерија на антибиотике катастрофална је претња и људима и здравству. Јер, у не тако далекој будућности пацијент би и после најбезазленије хируршке интервенције могао да умре од инфекције која не би могла да се заустави – упозорили су водећи британски медицински званичници.
При том су указали да је неопходна „глобална акција у истраживању и развоју нових антибиотика“, апелујући на то да се овим питањем више позабаве и Светска здравствена организација (WHO) и G8.
У неколико последњих деценија је, иначе, лансирано само неколико врста лекова из ове групе, док су истовремено инфекције тзв. „супербактеријама“ све учесталије.
Једна од најпознатијих супербактерија MRSA у Сједињеним Америчким Државама годишње усмрти безмало 19.000 особа, знатно више него AIDS. Отприлике исто толико људи страда од ове бактерије и у Европској унији.
Протеклих година су се појавили и типови туберкулозе и гонореје које су отпорне на све врсте познатих антибиотика. Међу новим „суперсупербактеријама“ најпознатија је NDM1, која је пре неку годину први пут откривена у Индији, а данас се са њом сусрећу лекари од Британије до Новог Зеланда.
Стручњаци истичу да се опасности може парирати појачаним праћењем и надзором над супербактеријама, селективнијим прописивањем антибиотика (само онда кад је то, заиста, нужно) ипобољшањем хигијене, нарочито у здравственим установама.
Најџел Браун, председник британског Друштва за општу микробиологију, напомиње да ће микробиолошке технике и нова достигнућа у области синтетичке биологије бити од кључне важности у будућуој борби против супербактерија.




















